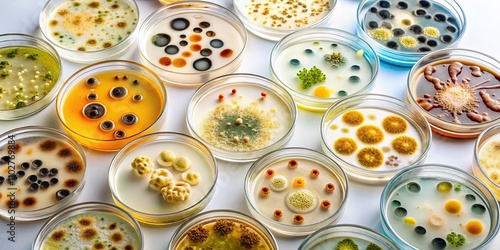
Various colonies of bacteria and fungus growing in petri dishes, bacteria, fungi, colonies, petri dish

More from this collection

An Outdoor Easter Egg Hunt Scene With Colorful Eggs Hidden Among Tall Grasses And Blooming Flowers With A Clear Blue Sky Overhead And Soft Sunlight Illuminating The Scene

An Outdoor Easter Egg Hunt Scene With Colorful Eggs Hidden Among Tall Grasses And Blooming Flowers With A Clear Blue Sky Overhead And Soft Sunlight Illuminating The Scene

An Elegant Easter Table Setting With Soft Pastel-colored Linens Fine China And A Centerpiece Of Spring Flowers And Decorated Eggs Set Against A Bright Sunlit Room

An Elegant Easter Dining Table Adorned With Fine China Crystal Glassware And An Assortment Of Spring Dishes Including Roasted Lamb And Fresh Salad Surrounded By Pastel Decorations

An Elegant Easter Dining Setup With A Rustic Wooden Table Pastel-colored Dishes And A Centerpiece Of Spring Flowers And Decorated Eggs Bathed In Soft Natural Light
View All from Collection
Explore more designs
Similar Wallpaper designs

A Vibrant Iftar Feast With Colorful Dishes, Fruits, And Desserts, Reflecting The Joy Of Ramadan
Various Colonies Of Bacteria And Fungus Growing In Petri Dishes, Bacteria, Fungi, Colonies, Petri Dish

A Vibrant Arrangement Of Diverse Dishes And Desserts Showcasing Culinary Artistry.
